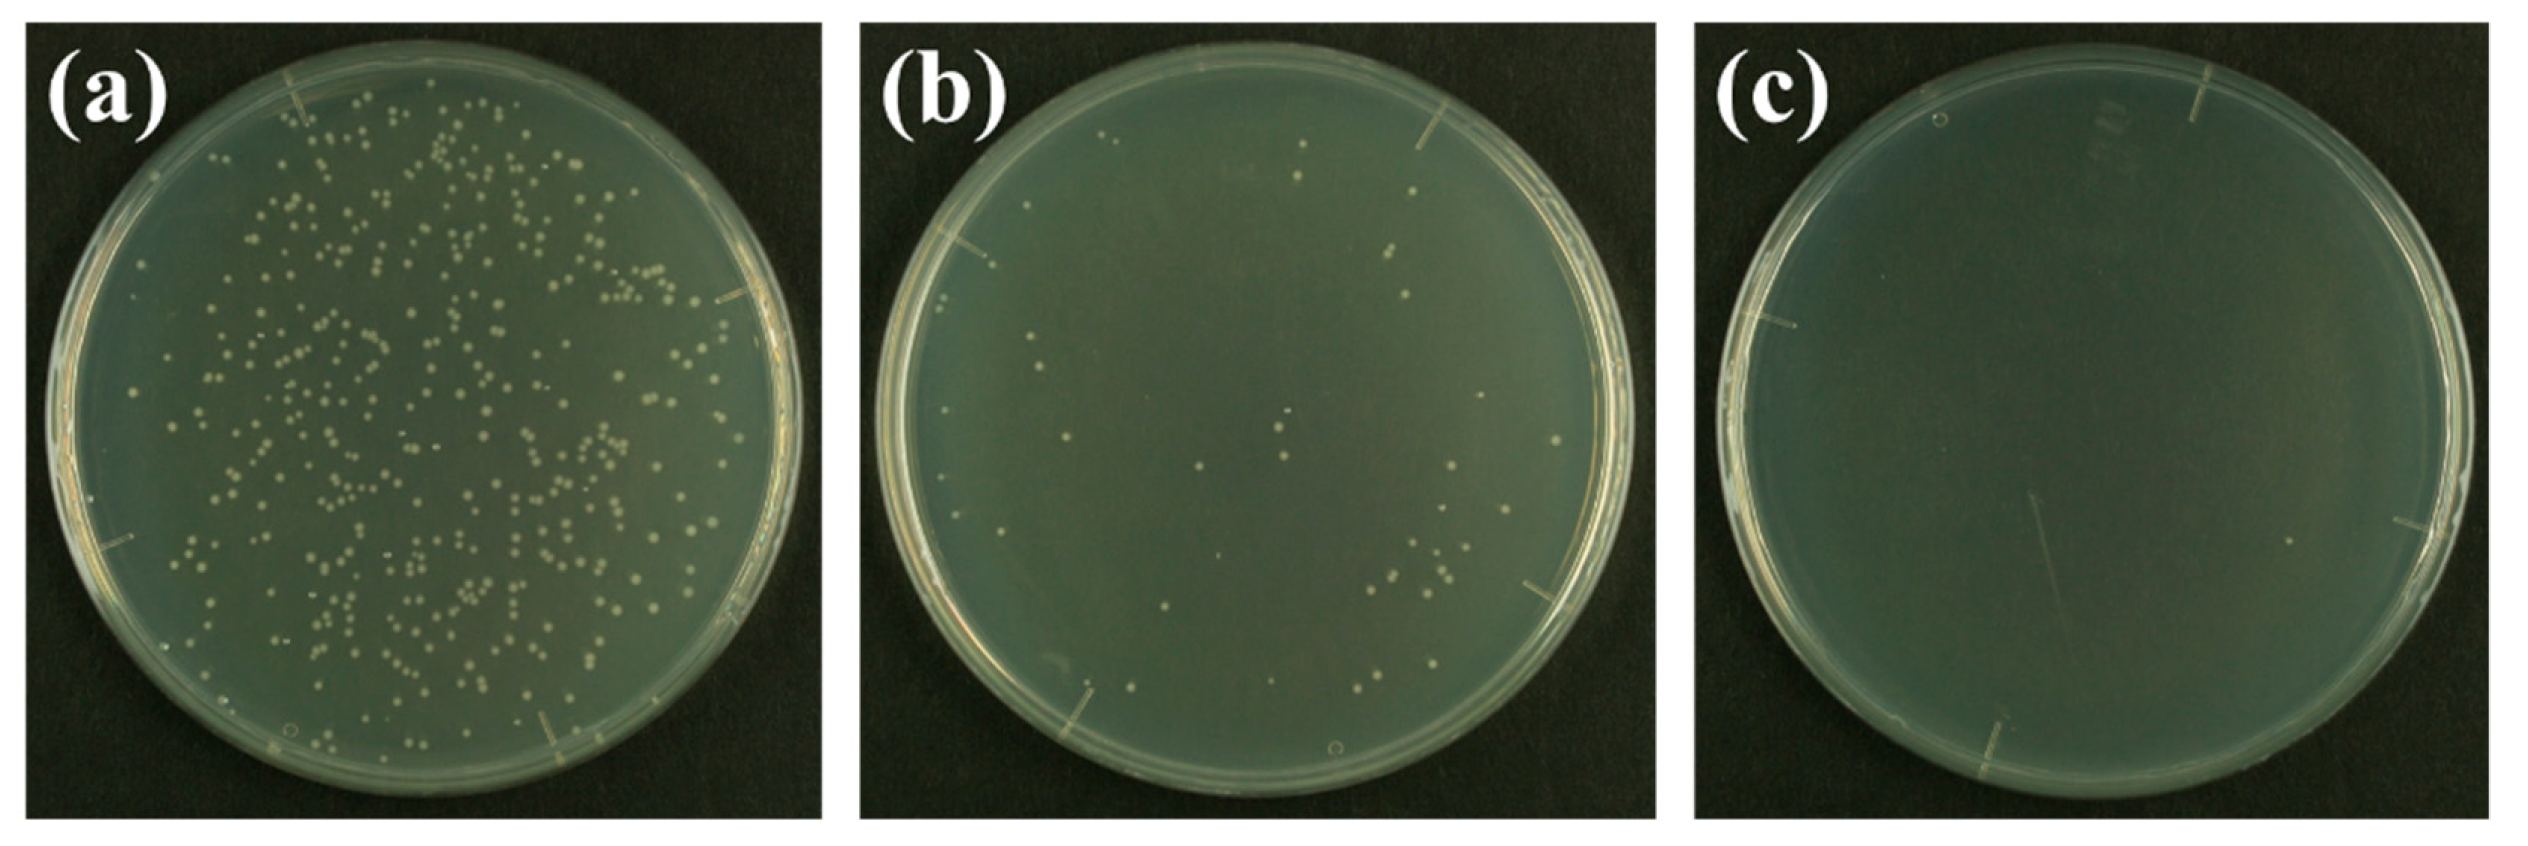

Instantaneous Water Purification by Deep Ultraviolet Light in Water Waveguide: Escherichia Coli Bacteria Disinfection
Abstract
:1. Introduction
2. Materials and Methods
2.1. Water Purification by DUV-LED Water Waveguide Method
2.2. Culturing and Enumeration of Microorganisms
3. Results and Discussion
3.1. Efficacy of Disinfection by DUV-LED Water-Waveguide Method
3.2. Theoretical Analysis of the Disinfection Rates
3.3. Portable Water Purification System with DUV-LED, Water Waveguide, and Photovoltaic Cell
4. Conclusions
Author Contributions
Funding
Acknowledgments
Conflicts of Interest
References
- Linden, K.G.; Malley, J.P.; Schmelling, D. Ultraviolet Disinfection Guidance Manual for the Final Long Term 2 Enhanced Surface Water Treatment Rule; EPA 815-R-06-007; U.S. Environmental Protection Agency, Office of Water: Washington, DC, USA, 2006. Available online: https://nepis.epa.gov/Exe/ZyPDF.cgi/600006T3. PDF?Dockey=600006T3.PDF (accessed on 24 April 2019).
- Crawford, M.H.; Banas, M.A.; Ross, M.P.; Ruby, D.S.; Nelson, J.S.; Boucher, R.; Allerman, A.A. Final LDRD Report: Ultraviolet Water Purification Systems for Rural Environments and Mobile Applications; SAND2005-7245; Sandia National Laboratories: Albuquerque, NM, USA, 2005. Available online: https://prod-ng.sandia.gov/techlib-noauth/access-control.cgi/2005/057245.pdf (accessed on 24 April 2019).
- Lazarova, V.; Savoye, P.; Janex, M.L.; Blatchley, E.R.; Pommepuy, M. Advanced wastewater disinfection technologies: State of the art and perspectives. Water Sci. Technol. 1999, 40, 203–213. [Google Scholar] [CrossRef]
- Owen, W.F. Energy in Wastewater Treatment; Prentice-Hall: Englewood Cliffs, NJ, USA, 1982; 373p. [Google Scholar]
- Gómez-López, M.D.; Bayo, J.; García-Cascales, M.S.; Angosto, J.M. Decision support in disinfection technologies for treated wastewater reuse. J. Clean. Prod. 2009, 17, 1504–1511. [Google Scholar] [CrossRef]
- Beaven, G.H.; Holiday, E.R.; Johnson, E.A. Optical Properties of Nucleic Acids and Their Components; Chargaff, E., Davidson, J.N., Eds.; The Nucleic Acids, Academic Press: New York, NY, USA, 1954; Volume 1, pp. 493–553. [Google Scholar]
- Rauth, A.M. The physical state of viral nucleic acid and the sensitivity of viruses to ultraviolet light. Biophys. J. 1965, 5, 257–273. [Google Scholar] [CrossRef]
- Meulemans, C.C.E. The basic principles of UV–disinfection of water. Ozone Sci. Eng. 1987, 9, 299–313. [Google Scholar] [CrossRef]
- Beck, S.E.; Wright, H.B.; Hargy, T.M.; Larason, T.C.; Linden, K.G. Action spectra for validation of pathogen disinfection in medium-pressure ultraviolet (UV) systems. Water Res. 2015, 70, 27–37. [Google Scholar] [CrossRef] [PubMed]
- Hall, J.D.; Mount, D.W. Mechanisms of DNA replication and mutagenesis in ultraviolet-irradiated bacteria and mammalian cells. Prog. Nucleic Acid Res. Mol. Biol. 1981, 25, 53–126. [Google Scholar] [PubMed]
- Sutherland, B.M.; Shih, A.G. Quantitation of pyrimidine dimer contents of nonradioactive deoxyribonucleic acid by electrophoresis in alkaline agarose gels. Biochemistry 1983, 22, 745–749. [Google Scholar] [CrossRef]
- Friedberg, E.C.; Walker, G.C.; Siede, W. DNA Repair and Mutagenesis; ASM Press: Washington, DC, USA, 2006; pp. 92–107. [Google Scholar]
- Ravanat, J.L.; Douki, T.; Cadet, J. Direct and indirect effects of UV radiation on DNA and its components. J. Photochem. Photobiol. B Biol. 2001, 63, 88–102. [Google Scholar] [CrossRef]
- Song, K.; Mohseni, M.; Taghipour, F. Application of ultraviolet light-emitting diodes (UV-LEDs) for water disinfection: A review. Water Res. 2016, 94, 341–349. [Google Scholar] [CrossRef]
- Taniyasu, Y.; Kasu, M.; Makimoto, M. An aluminium nitride light-emitting diode with a wavelength of 210 nanometres. Nature 2006, 441, 325–328. [Google Scholar] [CrossRef] [PubMed]
- Khan, A.; Balakrishnan, K.; Katona, T. Ultraviolet light-emitting diodes based on group three nitrides. Nat. Photonics 2008, 2, 77–84. [Google Scholar] [CrossRef]
- Nagasawa, Y.; Hirano, A. A review of AlGaN-based deep-ultraviolet light-emitting diodes on sapphire. Appl. Sci. 2018, 8, 1264. [Google Scholar] [CrossRef]
- Kneissl, M.; Seong, T.Y.; Han, J.; Amano, H. The emergence and prospects of deep-ultraviolet light-emitting diode technologies. Nat. Photonics 2019, 13, 233–244. [Google Scholar] [CrossRef]
- Beck, S.E.; Ryu, H.; Boczek, L.A.; Cashdollar, J.L.; Jeanis, K.M.; Rosenblum, J.S.; Lawal, O.R.; Linden, K.G. Evaluating UV-C LED disinfection performance and investigating potential dual-wavelength synergy. Water Res. 2017, 109, 207–216. [Google Scholar] [CrossRef] [PubMed]
- Li, G.; Wang, W.; Huo, Z.; Lu, Y.; Hu, H. Comparison of UV-LED and low pressure UV for water disinfection: Photoreactivation and dark repair of Escherichia coli. Water Res. 2017, 126, 134–143. [Google Scholar] [CrossRef] [PubMed]
- Xiao, Y.; Chu, X.N.; He, M.; Liu, X.C.; Hu, J.Y. Impact of UVA pre-radiation on UVC disinfection performance: Inactivation, repair and mechanism study. Water Res. 2018, 141, 279–288. [Google Scholar] [CrossRef] [PubMed]
- Hull, N.M.; Linden, K.G. Synergy of MS2 disinfection by sequential exposure to tailored UV wavelengths. Water Res. 2018, 143, 292–300. [Google Scholar] [CrossRef]
- Nyangaresi, P.O.; Qin, Y.; Chen, G.; Zhang, B.; Lu, Y.; Shen, L. Effects of single and combined UV-LEDs on inactivation and subsequent reactivation of E. coli in water disinfection. Water Res. 2018, 147, 331–341. [Google Scholar] [CrossRef]
- Matsumoto, T.; Kikojima, R.; Fukuoka, T.; Tatsuno, I.; Hasegawa, T. Total internal reflection of deep-ultraviolet light in a water waveguide and its application to water disinfection technologies. Water 2019, 11, 294. [Google Scholar] [CrossRef]
- Sutton, R.M. Demonstration Experiments in Physics; McGraw-Hill: New York, NY, USA, 1938; Volume 1, p. 385. [Google Scholar]
- Kshatriya, A. Water jet as a laser pipe. Am. J. Phys. 1976, 44, 604. [Google Scholar] [CrossRef]
- Hale, G.M.; Querry, M.R. Optical constants of water in the 200-nm to 200-µm wavelength region. Appl. Opt. 1973, 12, 555–563. [Google Scholar] [CrossRef] [PubMed]
- Daimon, M.; Masumura, A. Measurement of the refractive index of distilled water from the near-infrared region to the ultraviolet region. Appl. Opt. 2007, 46, 3811–3820. [Google Scholar] [CrossRef] [PubMed]
- Refractive Index Database. Available online: https://refractiveindex.info/ (accessed on 15 March 2019).
- Gross, A.; Stangl, F.; Hoenes, K.; Sift, M.; Hessling, M. Improved drinking water disinfection with UVC-LEDs for Escherichia coli and Bacillus subtilis utilizing quartz tubes as light guide. Water 2015, 7, 4605–4621. [Google Scholar] [CrossRef]
- Severin, B.F.; Suidan, M.T.; Engelbrecht, R.S. Kinetic modeling of U.V. disinfection of water. Water Res. 1983, 17, 1669–1678. [Google Scholar] [CrossRef]
- Oguma, K.; Rattanakul, S.; Bolton, J.R. Application of UV light–emitting diodes to adenovirus in water. J. Environ. Eng. 2016, 142, 04015082. [Google Scholar] [CrossRef]
- Rattanakul, S.; Oguma, K. Inactivation kinetics and efficiencies of UV-LEDs against Pseudomonas aeruginosa, Legionella pneumophila, and surrogate microorganisms. Water Res. 2018, 130, 31–37. [Google Scholar] [CrossRef]
- Oguma, K.; Kita, R.; Sakai, H.; Murakami, M.; Takizawa, S. Application of UV light emitting diodes to batch and flow-through water disinfection systems. Desalination 2013, 328, 24–30. [Google Scholar] [CrossRef]
- UV Irradiation Dosage Table. Available online: https://www.americanairandwater.com/uv-facts/uv-dosage.htm (accessed on 15 March 2019).
- Hijnen, W.A.; Beerendonk, E.F.; Medema, G.J. Inactivation credit of UV radiation for viruses, bacteria and protozoan (oo)cysts in water: A review. Water Res. 2006, 40, 3–22. [Google Scholar] [CrossRef]
- Chen, P.Y.; Chu, X.N.; Liu, L.; Hu, J.Y. Effect of salinity on medium- and low-pressure UV disinfection of Vibrio cholerae. Water Sci. Technol. 2018, 77, 655–661. [Google Scholar] [CrossRef]
- Clancy, J.L.; Bukhari, B.; Hargy, T.M.; Bolton, J.R.; Dussert, B.W.; Marshall, M.M. Using UV to inactivate Cryptosporidium. J. Am. Water Works Assoc. 2000, 92, 97–104. [Google Scholar] [CrossRef]
- Morita, S.; Namikoshi, A.; Hirata, T.; Oguma, K.; Katayama, H.; Ohgaki, S.; Motoyama, N.; Fujiwara, M. Efficacy of UV irradiation in inactivating Cryptosporidium parvum oocysts. Appl. Environ. Microbiol. 2002, 68, 5387–5393. [Google Scholar] [CrossRef] [PubMed]
- Shin, G.A.; Linden, K.G.; Arrowood, M.J.; Sobsey, M.D. Low-Pressure UV inactivation and DNA repair potential of Cryptosporidium parvum oocysts. Appl. Environ. Microbiol. 2001, 67, 3029–3032. [Google Scholar] [CrossRef]
- Craik, S.A.; Weldon, D.; Finch, G.R.; Bolton, J.R.; Belosevic, M. Inactivation of Cryptosporidium parvum oocysts using medium- and low-pressure ultraviolet radiation. Water Res. 2001, 35, 1387–1398. [Google Scholar] [CrossRef]
- Linden, K.G.; Shin, G.A.; Faubert, G.; Cairns, W.; Sobsey, M.D. UV disinfection of Giardia lamblia cysts in water. Environ. Sci. Technol. 2002, 36, 2519–2522. [Google Scholar] [CrossRef] [PubMed]
- Mofidi, A.A.; Meyer, E.A.; Wallis, P.M.; Chou, C.I.; Meyer, B.P.; Ramalingam, S.; Coffey, B.M. The effect of UV light on the inactivation of Giardia lamblia and Giardia muris cysts as determined by animal infectivity assay (P-2951-01). Water Res. 2002, 36, 2098–2108. [Google Scholar] [CrossRef]
- Oguma, K.; Katayama, H.; Ohgaki, S. Photoreactivation of Legionella pneumophila after inactivation by low- or medium-pressure ultraviolet lamp. Water Res. 2004, 38, 2757–2763. [Google Scholar] [CrossRef] [PubMed]
- Sommer, R.; Haider, T.; Cabaj, A.; Pribil, W.; Lhotsky, M. Time dose reciprocity in UV disinfection of water. Water Sci. Technol. 1998, 38, 145–150. [Google Scholar] [CrossRef]
- Würtele, M.A.; Kolbe, T.; Lipsz, M.; Külberg, A.; Weyers, M.; Kneissl, M.; Jekel, M. Application of GaN-based ultraviolet-C light emitting diodes–UV LEDs–for water disinfection. Water Res. 2011, 45, 1481–1489. [Google Scholar] [CrossRef] [PubMed]

| Type of Bacteria | Dose for 3-log (mJ/cm2) | Disinfection Constant (cm2/mJ) | Required DUV LED Intensity (mW) | Reference |
|---|---|---|---|---|
| E. coli | 8.1 | 0.37 | 2.43 | This study |
| V. cholerae | 2.2–3.0 | 1.0–1.36 | 0.66–0.9 | [1,36,37] |
| C. parvum | 2.0–6.0 | 0.5–1.5 | 0.6–1.8 | [38,39,40,41] |
| G. lamblia | 2.0–6.0 | 0.5–1.5 | 0.6–1.8 | [42,43] |
| L. pneumophila | 2.8–6.9 | 0.43–1.07 | 0.84–2.07 | [33,36,44] |
| P. aeruginosa | 7.0–16.0 | 0.19–0.43 | 2.1–4.8 | [14,33,35] |
© 2019 by the authors. Licensee MDPI, Basel, Switzerland. This article is an open access article distributed under the terms and conditions of the Creative Commons Attribution (CC BY) license (http://creativecommons.org/licenses/by/4.0/).
Share and Cite
Matsumoto, T.; Tatsuno, I.; Hasegawa, T. Instantaneous Water Purification by Deep Ultraviolet Light in Water Waveguide: Escherichia Coli Bacteria Disinfection. Water 2019, 11, 968. https://doi.org/10.3390/w11050968
Matsumoto T, Tatsuno I, Hasegawa T. Instantaneous Water Purification by Deep Ultraviolet Light in Water Waveguide: Escherichia Coli Bacteria Disinfection. Water. 2019; 11(5):968. https://doi.org/10.3390/w11050968
Chicago/Turabian StyleMatsumoto, Takahiro, Ichiro Tatsuno, and Tadao Hasegawa. 2019. "Instantaneous Water Purification by Deep Ultraviolet Light in Water Waveguide: Escherichia Coli Bacteria Disinfection" Water 11, no. 5: 968. https://doi.org/10.3390/w11050968
APA StyleMatsumoto, T., Tatsuno, I., & Hasegawa, T. (2019). Instantaneous Water Purification by Deep Ultraviolet Light in Water Waveguide: Escherichia Coli Bacteria Disinfection. Water, 11(5), 968. https://doi.org/10.3390/w11050968
